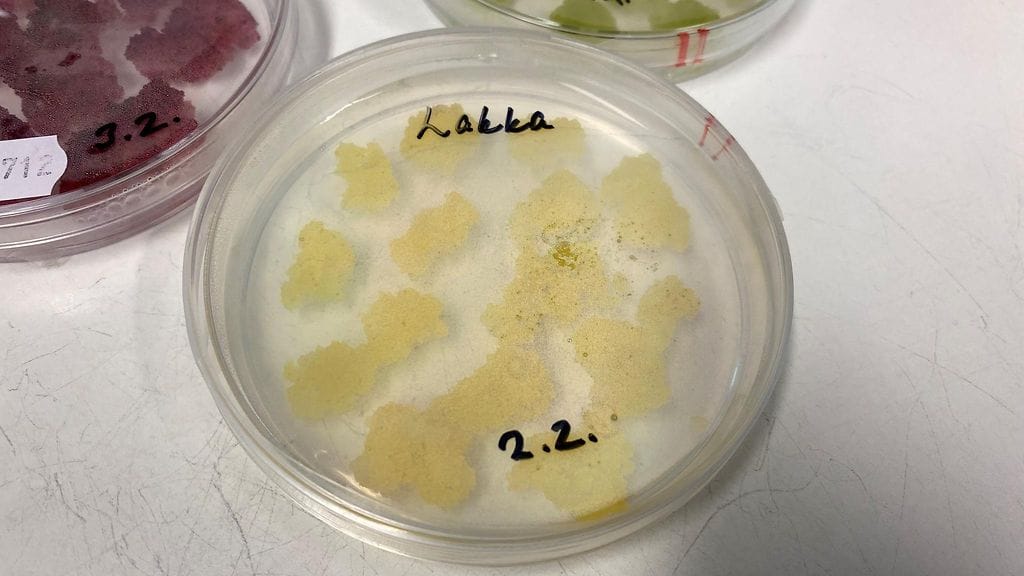

Hillassa ja monissa muissa marjoissa on tehokkaita antibakteerisia yhdisteitä, joita voidaan hyödyntää lääketieteessä. Tuoreen tutkimuksen mukaan hillan siemenen kuoresta eristetyt yhdisteet tehoavat sairaalabakteeria vastaan. Antibiooteille vastustuskykyisten bakteerien määrä kasvaa ja tarve löytää lääkkeitä niitä vastaan on suuri.
Hillalle on nyt löytynyt myös lääketieteellisiä käyttötarkoituksia. Tutkijat havaitsivat, että hillan siemenen kuoressa on aineita, jotka tehoavat pahamaineiseen MRSA-sairaalabakteeriin.
– Se on erittäin mielenkiintoinen löydös ja johtaa ilman muuta mielenkiintoisiin jatkotutkimuksiin. Tämä on yksi esimerkki siitä, että luonnosta löytyy paljon antimikrobisia aineita, toteaa HUSin osastonylilääkäri Teemu Kinnari.